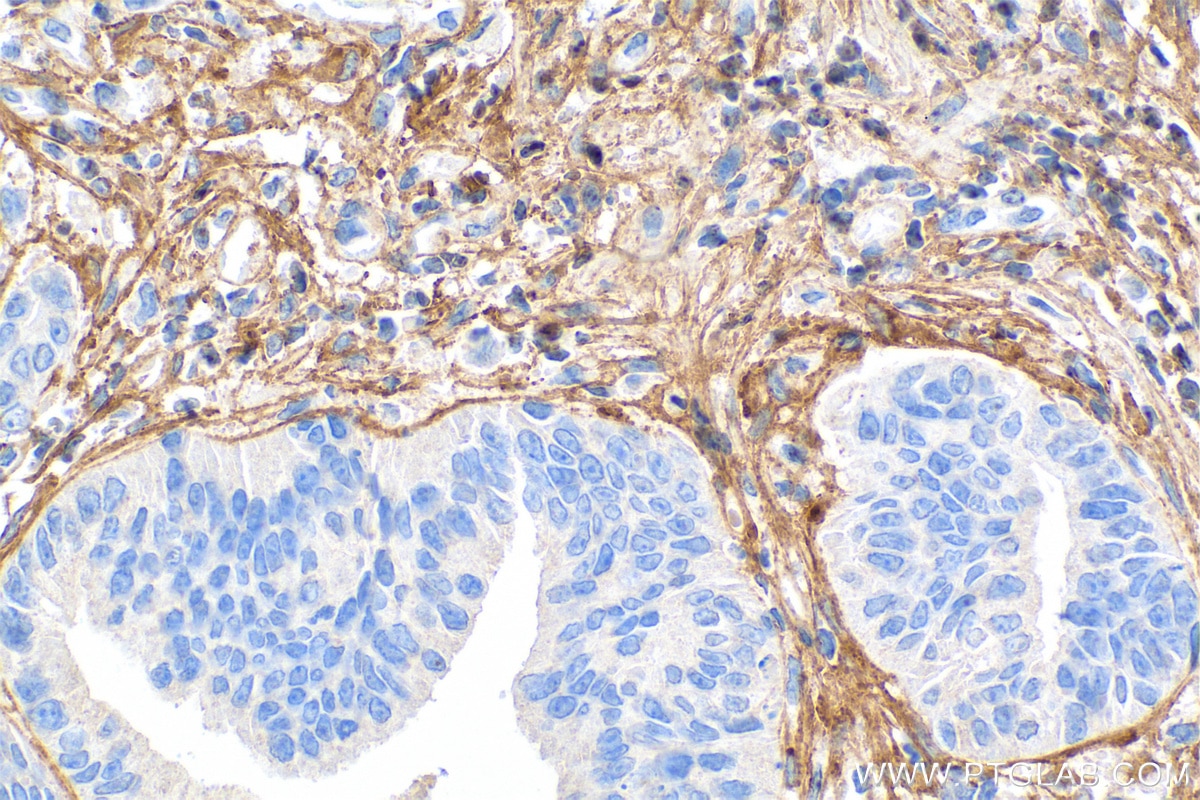
Immunohistochemistry (IHC) staining of human colon cancer tissue using Collagen Type I Monoclonal antibody (67288-1-Ig)

Tested Applications
| Positive WB detected in | pig colon tissue, human cervical cancer tissue, human placenta tissue, MG-63 cells, pig lung tissue, pig skin tissue |
| Positive IHC detected in | human breast cancer tissue, human colon tissue, human colon cancer tissue Note: suggested antigen retrieval with TE buffer pH 9.0; (*) Alternatively, antigen retrieval may be performed with citrate buffer pH 6.0 |
| Positive IF-P detected in | human colon cancer tissue, Human Fibroblasts |
| Positive IF/ICC detected in | U-251 cells |
Recommended dilution
| Application | Dilution |
|---|---|
| Western Blot (WB) | WB : 1:5000-1:50000 |
| Immunohistochemistry (IHC) | IHC : 1:2500-1:10000 |
| Immunofluorescence (IF)-P | IF-P : 1:200-1:800 |
| Immunofluorescence (IF)/ICC | IF/ICC : 1:400-1:1600 |
| It is recommended that this reagent should be titrated in each testing system to obtain optimal results. | |
| Sample-dependent, Check data in validation data gallery. | |
Published Applications
| WB | See 264 publications below |
| IHC | See 83 publications below |
| IF | See 99 publications below |
| CoIP | See 3 publications below |
Product Information
67288-1-Ig targets Collagen Type I in WB, IHC, IF/ICC, IF-P, CoIP, ELISA applications and shows reactivity with human, pig samples.
| Tested Reactivity | human, pig |
| Cited Reactivity | human, pig, rabbit, chicken, zebrafish |
| Host / Isotype | Mouse / IgG1 |
| Class | Monoclonal |
| Type | Antibody |
| Immunogen |
Peptide Predict reactive species |
| Full Name | collagen, type I, alpha 1 |
| Calculated Molecular Weight | 139 kDa |
| Observed Molecular Weight | 100-140 kDa,200kDa |
| GenBank Accession Number | NM_000088 |
| Gene Symbol | COL1A1 |
| Gene ID (NCBI) | 1277 |
| RRID | AB_2882554 |
| Conjugate | Unconjugated |
| Form | Liquid |
| Purification Method | Protein G purification |
| UNIPROT ID | P02452 |
| Storage Buffer | PBS with 0.02% sodium azide and 50% glycerol, pH 7.3. |
| Storage Conditions | Store at -20°C. Stable for one year after shipment. Aliquoting is unnecessary for -20oC storage. 20ul sizes contain 0.1% BSA. |
Background Information
Type I collagen, the major structural component of connective tissues such as skin, tendon and bone, is the most abundant and widely expressed collagen in humans (PMID: 7620364; 8645190; 9016532). Type I collagen is a heterotrimer comprising one alpha 2(I) and two alpha 1(I) chains which are encoded by the unlinked loci COL1A2 and COL1A1 respectively. Mutations in COL1A1 are associated with osteogenesis imperfecta types I-IV, Ehlers-Danlos syndrome type VIIA, Ehlers-Danlos syndrome Classical type, Caffey Disease and idiopathic osteoporosis. This antibody raised against a synthesized peptide corresponding to 1206-1218 aa of human pro-alpha 1 chain of type I collagen recognize collagen alpha-1(I) chain. The presence of unprocessed, intermediate, and mature chains of type I collagen was clearly detected only in static constructs. Indeed, in sponges cultured under perfusion the presence of type I collagen was mainly restricted to mature chains, suggesting that HACs were no longer actively producing type I collagen (PMID: 27584727). It is reported that the molecular weight is 200kDa(PMID: 28526934).
Protocols
| Product Specific Protocols | |
|---|---|
| IF protocol for Collagen Type I antibody 67288-1-Ig | Download protocol |
| IHC protocol for Collagen Type I antibody 67288-1-Ig | Download protocol |
| WB protocol for Collagen Type I antibody 67288-1-Ig | Download protocol |
| Standard Protocols | |
|---|---|
| Click here to view our Standard Protocols |
Publications
| Species | Application | Title |
|---|---|---|
Adv Mater Biodegradable Piezoelectric-Conductive Integrated Hydrogel Scaffold for Repair of Osteochondral Defects | ||
J Hematol Oncol Proteogenomic insights into the biology and treatment of pancreatic ductal adenocarcinoma | ||
Nat Cell Biol Persistence of a regeneration-associated, transitional alveolar epithelial cell state in pulmonary fibrosis. | ||
Adv Sci (Weinh) Tβ4-Engineered ADSC Extracellular Vesicles Rescue Cell Senescence Through Separable Microneedle Patches for Diabetic Wound Healing | ||
Adv Sci (Weinh) Silencing of NOTCH3 Signaling in Meniscus Smooth Muscle Cells Inhibits Fibrosis and Exacerbates Degeneration in a HEYL-Dependent Manner | ||
Small M2 Macrophage Membrane-Mediated Biomimetic-Nanoparticle Carrying COX-siRNA Targeted Delivery for Prevention of Tendon Adhesions by Inhibiting Inflammation |
Reviews
The reviews below have been submitted by verified Proteintech customers who received an incentive for providing their feedback.
FH Sai Sindhura (Verified Customer) (01-08-2026) | Collagen type 1 antibody is very good.
|
FH Ludovica (Verified Customer) (12-19-2025) | The antibody work nicely for both IF and WB. For IF, the antibody detects nicely both intracellular and extracellular collagen (although only after decellularization). For WB the signal is clear and without detection of other unspecific bands.
![]() |
FH Niky (Verified Customer) (02-26-2024) | Arrived very quickly on ice. However, didnt work for my tissue type
|
FH Udesh (Verified Customer) (12-22-2023) | Worked well for IF at 1:400
|
FH Niklas (Verified Customer) (11-08-2022) | great staining with even a high dilution factor
|
FH Ren Jie (Verified Customer) (06-22-2022) | Does not work for pepsin digested human collagen I
|
FH Hala (Verified Customer) (02-26-2021) | very good
|
FH Hala (Verified Customer) (02-23-2021) | very good
|